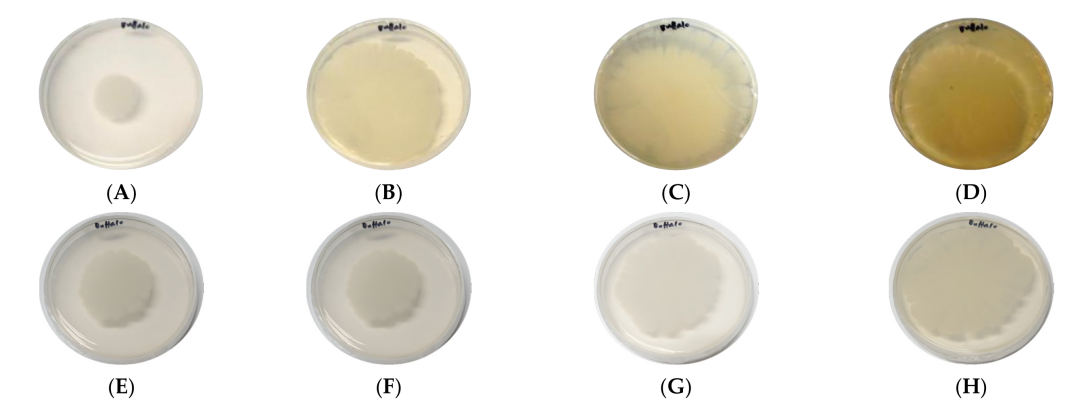
11.png

2022-06-20

《genes》
影响因子:4.096
近日,派森诺生物与华中农业大学合作,在微生物基因组领域的《genes》发表新研究成果!本研究旨在探索木质素降解酶编码基因在瘤胃微生物降解木质素的潜力,为揭示水牛降解木质素的机理提供思路。本文首次报道了水牛瘤胃中分离得到的蜡样芽孢杆菌(B. cereus)AH7-7能够降解木质素,并从全基因组水平揭示了木质素降解酶的编码基因。
研究背景
木质素是一种嵌在植物纤维素和半纤维素之间的极其稳定的芳香族三维聚合物,它会降低饲料的营养价值和利用,阻碍普通动物的消化能力。因此,微生物降解木质素已成为研究热点。目前已有研究表明变形菌和放线菌是具有降解木质素功能的主要细菌门,然而大多数木质素降解菌在全基因组水平上的基因组特征仍不清楚。
水牛对粗饲料具有较强的耐受性,是首个能高效降解木质素的哺乳动物。研究发现,水稻秸秆粗饲料在水牛瘤胃中粗蛋白质、干物质和有机物的消化率显著高于牛,酸性洗涤纤维的利用率也更高。水牛独特的瘤胃微生物系统是水牛在漫长的旱季没有绿草的情况下比牛长得多的原因,这种降解木质素的能力可能与水牛独特的瘤胃微生物区系有关。多项研究表明,水牛瘤胃中纤维素分解菌白色瘤胃球菌数量显著高于肉牛,且稻草饲喂水牛瘤胃中纤维素分解菌、蛋白分解菌和淀粉分解菌总数显著高于相同饲喂方式。本文假设水牛瘤胃木质素降解菌的能力来源于其独特的木质素降解酶系统,旨在从基因组学和酶学的角度探讨潜在木质素降解菌的降解木质素的能力,本研究结果对水牛降解木质素的机理有一定的指导意义。
研究材料与方法
1.实验材料:从水牛瘤胃中分离得到一株蜡样芽孢杆菌(B. cereus)AH7-7。
2.测序平台: Pacbio Sequel、Illumina Novaseq
3.分析内容:细菌基因组完成图测序、eggNOG数据库注释、KEGG数据库注释、碳水化合物酶活性分析(CAZYs)、愈创木酚显色实验、木质素降解实验等。
研究结果
菌株AH7-7的鉴定
形态学实验显示该菌菌落很大,呈蜡状、圆形、半透明和灰白色,表面粗糙,边缘不规则(图1A),显微镜下革兰氏染色显示为革兰氏阳性(图1B)。16S rRNA基因和gyrB基因的系统发育树显示,菌株AH7-7与蜡样芽孢杆菌最接近(图2)。根据菌落观察、革兰氏染色、生理生化数据、16S rRNA测序和gyrB基因测序结果,菌株AH7-7鉴定为B. cereus AH7-7。

图1 菌株AH7-7形态学鉴定

图2 16S和gyrB基因进化树构建分析
蜡样芽孢杆菌AH7-7的全基因组特征
全基因组测序结果表明,B. cereus AH7-7由一条染色体和一个环状质粒组成,分别为 5,328,700 bp和461,035 bp;GC含量和基因个数为别为:35.36%、5440个基因,33.67%、455个基因;全基因组圈图如图3所示。
表1 B.cereus AH7-7基因组特征


图3 B. cereus AH7-7基因组圈图
B.cereus AH7-7的eggNOG、KEGG和CAZYs数据库注释
eggNOG数据库中,染色体基因组中有1个ORF注释为漆酶基因,1个ORF注释为多铜氧化酶基因,5个ORF注释为细胞色素P450基因,8个ORF注释为单加氧酶基因,30个ORF注释为双加氧酶基因,7个ORF注释为过氧化氢酶基因,36个ORF注释为氧化酶基因,28个ORF注释为氧化还原酶基因,109个ORF注释为脱氢酶基因。在质粒基因组中,1个ORF被注释为多铜氧化酶基因,1个ORF被注释为细胞色素P450基因,1个ORF被注释为氧化还原酶基因,6个ORF被注释为脱氢酶基因。
表2 eggNOG功能注释中与木质素降解相关的酶

CAZY数据库中,总共45 ORF被注解为糖基转移酶基因,一个ORF多糖裂合酶基因,39个ORF作为碳水化合物的酯酶基因,基因12 ORF辅助活动,12个ORF carbohydrate-binding模块的基因和40个ORF糖苷水解酶基因(图4)。如表3所示,两个ORF注解为香草醛醇氧化酶基因,两个ORF,4-benzoquinone还原酶基因,三个ORF glucooligosaccharide氧化酶,壳寡糖氧化酶或纤维寡糖脱氢酶基因,三个orf为单加氧酶基因,两个orf为漆酶或二氢地丁氧化酶基因。

图4 碳水化合物酶活性注释结果统计
表3 B.cereus AH7-7辅助活性家族相关基因

在kegg数据库中,B.cereus AH7-7基因组中有15个基因与苯丙氨酸代谢有关4个与氯环己烷和氯苯降解相关,11个与苯甲酸酯降解有关,7个与细胞色素P450代谢有关,6个与苯乙烯代谢有关;8个降解为萘,1个降解为硝基甲苯,7个降解为氨基苯甲酸酯,4个降解为二甲苯。

图5 B.cereus AH7-7在芳香降解相关KEGG通路中富集的基因数量
蜡样芽孢杆菌AH7-7漆酶分泌
愈创木酚培养基对B.cereus AH7-7漆酶分泌量的测定。菌株培养第4天开始出现轻微的红褐色晕,第10天逐渐加深,第15天颜色发育明显。
图6 愈创木酚与硫酸盐-木质素还原的显色反应
蜡样芽孢杆菌AH7-7的硫酸盐-木质素降解
B.cereus AH7-7降解硫酸盐-木质素的还原过程如图7所示,在培养的前两天,培养基中硫酸盐木质素含量略有下降。幼仔6 d后,硫酸盐木质素含量显著降低(25.9%)。

图7 硫酸盐木质素还原图
研究结论
本研究表明,从水牛瘤胃中分离得到的B.cereusAH7-7具有降解木质素的能力。该菌具有漆酶、细胞色素P450和香兰素醇氧化酶基因,这些基因可以产生参与木质素降解的酶。B.cereus AH7-7的漆酶分泌量和降解硫酸盐木质素的能力随时间增加而增加。
本研究的denovo测序和部分数据分析由上海派森诺生物科技有限公司完成。如需进一步讨论,欢迎发邮件或者致电我们哟(邮箱地址:microsupport@personalbio.cn,联系电话:025-56165883-832)!
文章索引:Zhong H, Zhou J, Wang F, et al. Whole-Genome Sequencing Reveals Lignin-Degrading Capacity of a Ligninolytic Bacterium (Bacillus cereus) from Buffalo (Bubalus bubalis) Rumen[J]. Genes, 2022, 13(5): 842.